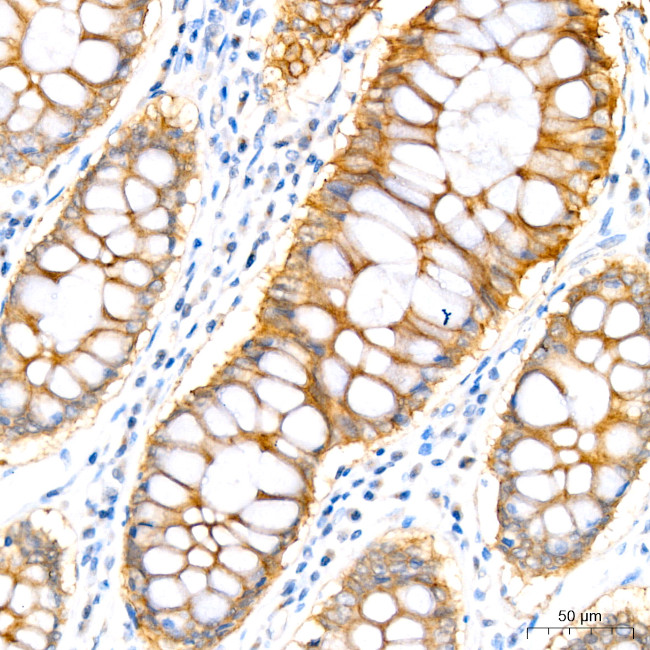
PER1 Antibody in Immunohistochemistry (Paraffin) (IHC (P))

Search
Invitrogen
PER1 Recombinant Rabbit Monoclonal Antibody (2Y1M7)
{{$productOrderCtrl.translations['antibody.pdp.commerceCard.promotion.promotions']}}
{{$productOrderCtrl.translations['antibody.pdp.commerceCard.promotion.viewpromo']}}
{{$productOrderCtrl.translations['antibody.pdp.commerceCard.promotion.promocode']}}: {{promo.promoCode}} {{promo.promoTitle}} {{promo.promoDescription}}. {{$productOrderCtrl.translations['antibody.pdp.commerceCard.promotion.learnmore']}}
图: 1 / 7
PER1 Antibody (MA5-58132) in IHC (P)







Please note: We are reviewing Western blot images included in the antibody testing data in our catalog, including those provided by third parties. Unless expressly labeled or annotated as “raw-unedited”, Western blot images included in the antibody testing data in our catalog may have been edited, optimized or otherwise adjusted for presentation.
产品信息
MA5-58132
种属反应
宿主/亚型
Expression System
分类
类型
克隆号
抗原
偶联物
形式
浓度
规格
纯化类型
保存液
内含物
保存条件
运输条件
RRID
产品详细信息
Immunogen sequence: MSGPLEGADG GGDPRPGESF CPGGVPSPGP PQHRPCPGPS LADDTDANSN GSSGNESNGH ESRGASQRSS HSSSSGNGKD SALLETTESS KSTNSQSPSP PSSSIAYSLL SASSEQDNPS TSGCSSEQSA RARTQKELMT ALRELKLRLP PERRGKGRSG TLATLQYALA CVKQVQANQE YYQQWSLEEG EPCSMDMSTY
靶标信息
Circadian rhythmicity is a basic property of phylogenetically diverse organisms which range from animals and plants, to fungi. Regulation of endogenous biological clocks is regulated at the genetic level by a protein-mediated, autoregulatory feed-back loop. In mammals, several genes that encode members of the basic helix-loop helix (bHLH) PAS (PER-ARNT-SIM) transcription factor family have been shown to play a significant role in regulating circadian oscillations. Transactivation of CLOCK-induced genes is mediated via an E box enhancer (CACGTG) found upstream of target genes. CLOCK-ARNT3 heterodimers bind to E box regulatory elements and stimulate gene transcription. CLOCK has been shown to transactivate the mammalian homolog of Drosophila per. PER, in concert with the product of the mammalian timeless gene (TIM), negatively regulates its own transcription by blocking the activity of the CLOCK-BMAL1 transactivation complex.
仅用于科研。不用于诊断过程。未经明确授权不得转售。
篇参考文献 (0)
生物信息学
蛋白别名: Circadian clock protein PERIOD 1; Circadian pacemaker protein Rigui; hPER1; mPER1; Period circadian protein homolog 1; period homolog 1
基因别名: KIAA0482; m-rigui; mPer1; PER; PER1; RIGUI
UniProt ID: (Mouse) O35973
Entrez Gene ID: (Mouse) 18626